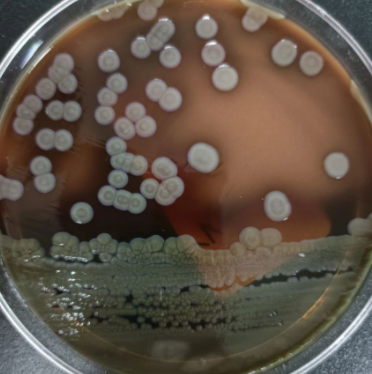
Ramlibacter Ginsenosidimutans

网站主页
Ramlibacter Ginsenosidimutans
Ramlibacter Ginsenosidimutans
Ramlibacter Ginsenosidimutans
Ramlibacter Ginsenosidimutans
询价
1支
起订
北京 更新日期:2026-02-24
产品详情:
- 中文名称:
- Ramlibacter Ginsenosidimutans
- 英文名称:
- Ramlibacter Ginsenosidimutans
- 品牌:
- 微生物菌种查询网
- 产地:
- 中国
- 保存条件:
- 2-8度
- 纯度规格:
- 99.99%
- 产品类别:
- 化工
- 别名:
- KCTC 22276
- 用途:
- 科研
- 产品规格:
- 冻干物/培养物
- 主要用途:
- 研究
- 是否危险化学品:
- 否
- 货号:
- Bio-80661
公司简介
北京百欧博伟生物技术有限公司是集微生物菌种、菌种,ATCC菌种、细胞、培养基为一体的大型微生物查询类网站,自设设备及技术的微生物菌种保藏中心!与国内外多家研制单位,生物医药,第三方检测机构,科研院所有着良好稳定的长期合作关系!欢迎广大客户来询!
| 成立日期 | (14年) |
| 注册资本 | 500万人民币 |
| 员工人数 | 10-50人 |
| 年营业额 | ¥ 500万-1000万 |
| 经营模式 | 贸易,服务 |
| 主营行业 | 色谱分析,微生物学,细胞生物学,第三方检测技术服务,微生物检测仪器 |
Ramlibacter Ginsenosidimutans相关厂家报价
-

- Rhodanobacter Ginsenosidimutans
- 北京百欧博伟生物技术有限公司
- 2026-02-12
- 询价
-

- Anseongella Ginsenosidimutans
- 北京百欧博伟生物技术有限公司
- 2025-10-20
- 询价